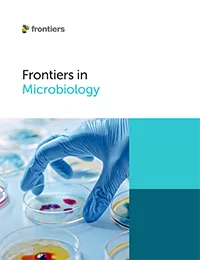
Frontiers in Microbiology

更多生命科学期刊
Frontiers in Agronomy
Explores research focusing on cropping systems for food, feed, fuel, and fibre production.
Acta Biochimica Polonica
The official journal of Polskie Towarzystwo Biochemiczne (Polish Biochemical Society).
Acta Virologica
The Open Access journal of the Biomedical Research Centre of the Slovak Academy of Sciences.
Frontiers in Amphibian and Reptile Science
Explore cutting-edge herpetology research on amphibians and reptiles, from evolution to conservation.
Frontiers in Antibiotics
Discover research exploring solutions to antibiotic resistance, development and delivery to improve the health of the global population.
Frontiers in Aquaculture
Explore research related to the production of aquatic animals and plants, and all farming aspects, including production, sustainability and economics.
Frontiers in Arachnid Science
Explore research on the ways in which arachnids interact with human society, from medicine to agriculture, and the benefits they have upon the ecosystem.
Frontiers in Aging
Explore research that advances our understanding of human aging and the fundamental link with age-related diseases.
Frontiers in Animal Science
Explore research on sustainable animal science, covering topics such as welfare, nutrition and genetics.
Frontiers in Bioengineering and Biotechnology
Research exploring and advancing biological therapies, devices, and technologies to improve our lives.
Frontiers in Bacteriology
Explore research on bacteriology and host-pathogen interactions, aiming to bridge the gap between molecular and clinical aspects.
Frontiers in Bee Science
Explore research on bee biology, covering topics such as health and conservation, supporting efforts to conserve and manage the world's bee populations.
Frontiers in Biomaterials Science
Explore research on biomaterials science, integrating chemistry, biology, and engineering to advance biomedical innovations.
Frontiers in Biophysics
Explore research on biophysics, bridging physical and biological sciences to understand the mechanics of biological systems.
Frontiers in Bird Science
Explore research on bird science, covering topics such as behavior, ecology, conservation and migration.
British Journal of Biomedical Science
Official journal of the Institute of Biomedical Science (IBMS).
Frontiers in Bioinformatics
Explore research on bioinformatics tools and applications driving biological data analysis and discovery.
Frontiers in Cell and Developmental Biology
An interdisciplinary journal that focuses on the fundamental biological processes of life.
Frontiers in Cellular Neuroscience
Explore peer-reviewed research on cellular mechanisms of neural and glial function across species in this neuroscience journal.
Frontiers in Cellular and Infection Microbiology
Explore peer-reviewed research on microbial pathogenesis, host-microbe interactions, and infection biology in this journal.
Frontiers in Cell Death
Discover cutting-edge research on apoptosis, necroptosis, and cell death pathways in this multidisciplinary journal.
Frontiers in Chemical Biology
Explore interdisciplinary research at the chemistry-biology interface, including drug design, omics, and bioinorganic systems.
Frontiers in Ecology and Evolution
Explore open‑access, peer‑reviewed research across ecology, evolutionary biology, biogeography, conservation and ecosystem dynamics.
Frontiers in Epigenetics and Epigenomics
Explore open‑access research in epigenetics and epigenomics, uncovering cellular memory, gene regulation and disease mechanisms.
Frontiers in Ethology
Explore open-access research in ethology, advancing our understanding of the mechanisms, processes, ecology, and evolution of animal behavior.
Experimental Biology and Medicine
A global, peer-reviewed journal dedicated to the publication of multidisciplinary and interdisciplinary research in the biomedical sciences.
Frontiers in Forests and Global Change
Explore research that advances our understanding of how forests function, spanning from molecules to ecosystems to the biosphere.
Frontiers in Fungal Biology
Explore open-access research covering the different fields of mycology - agricultural, medical and applied industrial - to decipher the interactions of fungi.
Frontiers in Fish Science
Explore open‑access research in fish science, covering fish biology, conservation, ecology and evolutionary insights to protect fish species and their habitats.,
Frontiers in Food Science and Technology
Explore open‑access research in food science and technology, covering innovations across food systems, materials, engineering and safety.
Frontiers in Freshwater Science
Explore research on mitigating environmental health and aquatic diseases to accelerate the preservation and conservation of our freshwater bodies and ecosystems
Frontiers in Genetics
Explore research from the world's most cited genetics and heredity journal, advancing our understanding of genes from humans to plants and other model organisms.
Frontiers in Genome Editing
Explore open-access research on existing and emerging genome editing technologies and their implications across wide-ranging areas of research.
Frontiers in Horticulture
Explore open‑access research in horticulture with studies on crops, plant health, soils, production systems and sustainability.
Frontiers in Industrial Microbiology
Explore open access research that advances the use of microorganisms in industrial processes, from agriculture to pharmaceuticals.
Frontiers in Insect Science
Explore open access research on insect biology, behavior, ecology and applications shaping ecosystems and industries.
Frontiers in Lab on a Chip Technologies
Explore open access research addressing the fabrication and use of micro and nano-scale technology in areas such as engineering and computer science.
Frontiers in Malaria
Explore open access research on all aspects of malaria, from transmission to treatment and prevention for effective control strategies.
Frontiers in Mammal Science
Explore open access research on mammal science, including evolution, behavior, physiology and conservation of mammals.
Frontiers in Membrane Science and Technology
Explore open access research in membrane science and technology, covering structure, applications and separation processes.
Frontiers in Microbiomes
Explore open access research in microbiomes, uncovering how microbial communities shape health, environment and ecosystem dynamics.
Frontiers in Molecular Medicine
Explore open access research in molecular medicine, translating molecular insights into diagnostics and therapeutics for human disease.
Frontiers in Marine Science
Explore open access research on marine science, investigating ocean systems, biodiversity, ecology and global ocean health.
Frontiers in Microbiology
Explore open access research in microbiology, advancing microbial science for health, agriculture and the environment.
Frontiers in Molecular Biosciences
Explore open access research in molecular biosciences, probing molecular mechanisms and biological processes across life forms.
Frontiers in Natural Products
Explore open access research in natural products, spanning evolution, synthesis, functions and discovery of bioactive molecules.
Frontiers in Nutrition
Explore open access research in nutrition, covering clinical nutrition, metabolism, food science, policy, sustainability and public health nutrition.
Frontiers in Network Physiology
Explore open access research in network physiology, mapping how physiological systems interact to maintain health or contribute to disease.
Frontiers in Ocean Sustainability
Explore open access research in ocean sustainability, integrating ecology, policy and technology to support sustainable use and protection of marine environments.
Frontiers in Parasitology
A go-to forum for the most important challenges in parasitology and parasitism - exploring and mitigating the impact of parasites on plants, animals, humans, and the wider society.
Pathology and Oncology Research
the Open Access journal of the Lajos Arányi Foundation. POR focuses on advances on the fields of experimental and clinical oncology, and pathology, bridging the gap between basic research and clinical medicine.
Frontiers in Photobiology
A multidisciplinary journal advancing photobiology research and practical use in physiology, agriculture, medicine, biotech, food science, and ecology.
Frontiers in Plant Physiology
A multidisciplinary journal focused on advancing research in all areas of plant physiology, from morphogenesis to evolution and cell and molecular biology.
Frontiers in Protistology
Explores the varied protistan groups and their impacts, from phytoplankton to parasites and symbionts, including marine, freshwater and terrestrial ecosystems
Frontiers in Pharmacology
The world's most cited pharmacology and pharmacy journal, advancing global pharmacological discoveries to prevent and treat human disease.
Frontiers in Physiology
The most cited physiology journal, promoting a multidisciplinary approach to the physiology of living systems - from the subcellular and molecular domains to the intact organism and its interaction with the environment.
Frontiers in Plant Science
The most cited plant science journal, advancing our understanding of plant biology for sustainable food security, functional ecosystems and human health.
Frontiers in RNA Research
A multidisciplinary journal exploring the chemistry, generation and functional roles of RNA molecules in biological processes to advance our knowledge on RNA involvement in genetics, genomics and epigenomics
Frontiers in Science
Transformational research, frameworks, and paradigms for accelerating solutions to global challenges - enriched by unique hubs of complementary content that engage and empower communities across all areas of science, policy, and society.
Spanish Journal of Soil Science
The official journal of the Spanish Society of Soil Science. SJSS is a peer-reviewed journal with open access for the publication of Soil Science research.
Frontiers in Synthetic Biology
A multidisciplinary journal focused on advancing research on biology and digital technologies by altering metabolism to produce high-value products for applications ranging from biofuels to plant derived compounds.
Frontiers in Synaptic Neuroscience
Part of a popular neuroscience journal series which advances our understanding of the synaptic structure, function, plasticity and alterations in disease.
Frontiers in Sustainable Food Systems
Aligned with the UN Sustainable Development Goals, this journal explores the intersection of food systems, science and practice of sustainability including its environmental, economic and social justice dimensions.
Frontiers in Soil Science
A forum for excellence in soil science - from plant-soil interactions to mathematical modelling on soil processes - deepening our knowledge of the subject.
Frontiers in Systems Biology
An exciting journal integrating theory, experimentation, and practical application across biology and biomedicine to tackle some of the most urgent questions we face as humans.
Transplant International
TI aims to be the premier journal publishing basic science and clinical developments in organ replacement medicine, including all aspects of transplantation, organ reconditioning, cell therapy, regenerative medicine, bioengineering and artificial organs.
Frontiers in Transplantation
A multidisciplinary journal which communicates bench-to-bedside progress and breakthroughs in the ever-evolving transplant field, to improve clinical practice and save lives.
Frontiers in Tropical Diseases
Exploring the pathophysiology and control of tropical diseases with a focus on integrative prevention, control, and treatment methods, and the associated challenges in vulnerable populations.
Frontiers in Tuberculosis
A multidisciplinary journal focused on understanding the mechanisms behind the development, progression, treatment of tuberculosis and non-tuberculous mycobacterial infections.
Frontiers in Toxicology
A multidisciplinary journal which presents the latest research on the adverse effects of substances, particles and mixtures on living organisms.
Frontiers in Veterinary Science
The second most-cited veterinary science journal, bridging animal and human health with a comparative approach to medical challenges. It explores innovative biotechnology and therapy for improved health outcomes.
Frontiers in Virology
A multidisciplinary journal which explores all biological and molecular aspects of viruses, with a focus on innovative investigative and analytical systems.